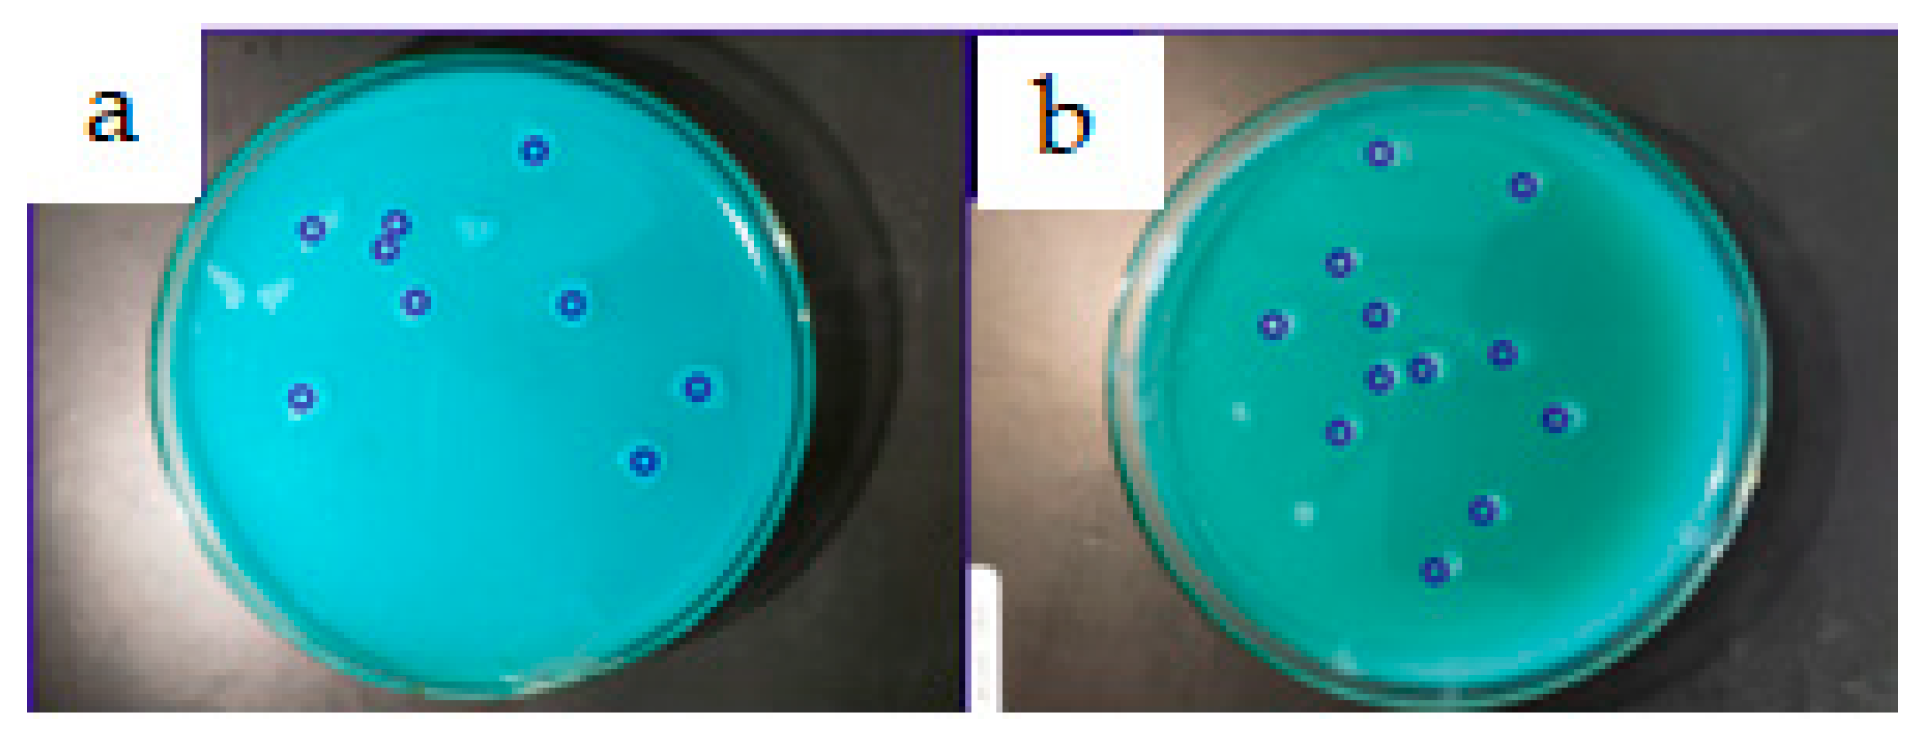
Fermentation 09 00207 g006

Abstract
The demand for biosurfactants (BS) produced by yeast for use in industrial processes and products is increasing. Therefore, there has been an increase in the number of publications related to characterization of surfactant compounds produced by yeasts generally recognized as safe (GRAS), which has enabled their application in several industries, including the pharmaceutical and food industries. However, some of these studies use techniques that are not accurate or are no longer essential because of advancements in new technologies. Given the industrial importance of yeasts and their potential to produce BS, this study reviews the production of BS by this microorganism and the most recent industrial applications of BS. It also critically reviews a wide range of techniques used in screening of BS-producing strains, as well as those used in recovery, purification, and characterization of these surfactant compounds produced by yeasts. This review introduces diverse methodologies that are indispensable for the study of BS produced by yeast in an effort to advance BS design, synthesis, and application and introduces new perspectives in the research of these compounds to overcome the obstacles present in this field.
1. Introduction
Surfactants are chemical compounds found between aqueous phases with different degrees of polarity and hydrogen bonds [1,2]. These surfactants, depending on their origin, can be synthetic (surfactants) or natural (biosurfactants). Biosurfactants (BS) are composed of amphiphilic molecules with hydrophilic and hydrophobic fractions [3,4]. Their polar portion can be ionic (cationic or anionic), non-ionic, or amphoteric (possess both positive and negative charges depending on the environment in which they are present), and their non-polar portion commonly comprises a hydrocarbon chain (Figure 1). These characteristics give BS the ability to reduce surface- and interfacial stress and form emulsions, which are hydrocarbons solubilized in water or vice versa [5,6].
Figure 1.
Types of biosurfactants based on the polarity of the head group. Source: the author.
BS have aroused considerable interest in recent decades due to properties that make them useful in different industrial activities that involve emulsification, detergency, lubrication, foaming, dispersion, or solubilization in different phases. In addition, BS have advantages over synthetic surfactants because they are complex molecules with specific functional groups and have high biodegradability (i.e., they are easily degraded by microorganisms in water and soil), stability, and efficacy in a variety of environmental conditions (temperature, pH, and salinity), as well as low toxicity and biocompatibility [7,8,9,10].
BS can be used in several industrial sectors, partially or totally replacing chemical surfactants in widely consumed products [11], such as laundry detergents [12], household cleaning products, personal hygiene products [13,14], and cosmetics [15]. In the medical field, BS can serve as antimicrobials, antitumor agents, and anti-inflammatory agents because of their bioactivity [16,17]. In agriculture, BS can improve soil quality by removing heavy metals and inhibiting activity of several pests—such as fungi, weeds, insect larvae, and nematodes—that cause drastic reductions in profits [18]. BS also play a significant role in other fields, acting as larvicidal agents against larvae of the Aedes aegypt mosquito—which causes diseases such as Dengue, Zika, and Chikungunya [16,19]—and used to stabilize silver and gold nanoparticles, even in the absence of conventional chemical agents [20,21].
Different microorganisms can produce BS, but use of yeast offers the great advantage of not presenting a risk of toxicity or pathogenicity; therefore, biotechnological processes based on the yeast species are granted the generally recognized as safe (GRAS) status given by the Food and Drug Administration (FDA) [22]. These microorganisms can produce BS from oleaginous substrates, including agro-industrial residues—such as glycerol, corn steeping liquor, and residual frying oil—which makes industrial application of BS produced by yeasts viable and reduces production costs [23,24]. For example, green technologies may emerge as important tools for lignocellulosic biorefineries as these are alternative routes for short-term BS production [25].
Considering reports of increased use of BS in diverse industrial sectors and growing interest in BS production and characterization, this review discusses the methods of production, detection, classification, recovery, purification, and characterization of BS produced by yeasts. This article also presents an overview of use of these natural compounds given their desirable properties.
2. Advantages and Disadvantages of Biosurfactants in Relation to Synthetic Surfactants
Surfactants are extensively used in homes and industries on a daily basis, generating a market value of USD 39,901 million worldwide in 2019 that is expected to grow to USD 52,417 million by 2025 [26]. However, despite the universality of these components, synthetic surfactants cause environmental impacts that are generally neglected since most products that incorporate them are sold as disposable and are released into the environment after disposal. Synthetic surfactants that reach aquatic environments have been reported as organic pollutants and have been detected in surface waters [27].
Synthetic surfactants in industrial, domestic, and medical wastewater become difficult to remove in water treatment plants because of the molecular properties of surfactants [28], which cause residual surfactant content to remain even after treatment. Furthermore, surfactants can also increase spread of different pollutants, such as heavy metals, causing extra problems for the ecosystem [26].
In this context, biosurfactants have emerged as an alternative to synthetic surfactants (Figure 2). In contrast to synthetic surfactants, biosurfactants are composed of natural molecules, such as lipids, sugars, and proteins, and are produced by microorganisms. This unique composition gives them preferable properties, such as better biodegradability and lower toxicity. They are able to maintain their surface properties as well as synthetic surfactants [29,30], increasing their acceptability; they generally do not pose an ecological threat.
Figure 2.
Synthetic surfactants and biosurfactants: comparative advantages and disadvantages.
3. Biosurfactants Produced by Yeast
Yeasts have gained greater visibility in BS studies over bacteria as bacterial BS may have restricted use in the pharmaceutical and food industries due to their pathogenic and/or opportunistic characteristics. In addition, some yeasts have a higher rate of substrate conversion, producing higher amounts of BS than bacteria [31,32]. Most yeast species also offer the advantage of having GRAS status as they do not present a risk of toxicity or pathogenicity, allowing their products to be applied in a wide range of industrial sectors [33,34].
Regarding the growing industrial demand for yeasts for several applications (Figure 3), the genus Candida stands out for its diversity of species producing biosurfactants reported in the literature [1,35]. However, several other yeast genera have been reported recently for their potential as producers of BS—such as Rhodotorula [36], Saccharomyces [37], and Wickerhamomyces [16,38]—that exhibit flocculent, environmental, antimicrobial, antioxidant, and larvicidal properties. In addition, their recovery percentages are higher compared to the yields of BS originating from other microorganisms. Several studies have described increasing yields of production of BS in yeast fermentation, varying between 10 and 120 g/L [39,40,41,42]. For example, high yields of BS (120 g/L) produced by Candida bombicola using a residue of the meat processing industry have been reported [41]. On the other hand, a study showed that bacterium Klebseilla sp. produced a BS yield in the range of 0.1–6.9 g/L [43].
Figure 3.
Publications on the main genera of BS-producing yeasts in the last 5 years. Data collected from Google Scholar searches on the number of articles published from 2018 to 2022 (n = 9020), excluding reviews.
Yeasts are able to grow both on water-immiscible substrates, such as vegetable oils and hydrocarbons, and on water-soluble compounds, such as carbohydrates and glycerol [33,44]. The conditions of cultivation and composition of the medium determine the production and composition of the BS since hydrophobic substrates have high moisture and protein content that cause their rapid degradation and influence survival of producing microorganisms, which use the set of carbon and energy sources for growth [45,46]. This combination of carbon sources with insoluble substrates facilitates intracellular diffusion because it increases solubility of water-insoluble compounds and facilitates their transport to the cell [47]. Table 1 shows BS production by different yeasts from different substrates, highlighting the vast diversity of substrate possibilities.
Table 1.
Yeast-producing BS using different substrates.
One of the first and most relevant studies of production of yeast BS was by Pareilleus (1979) [56], in which yeast Candida lipolytica was shown to produce a complex extracellular polymer with a protein, a lipid, and a carbohydrate portion and exhibited emulsifying properties when grown in n-tetradecane or a mixture of linear hydrocarbons. Some years later, Cooper and Paddock (1984) [57] used two types of carbon sources—carbohydrate and vegetable oil—to obtain large yields of BS from Candida bombicola (formerly called Torulopsis bombicola), producing a mixture of glycolipids that were found by thin-layer chromatography, showing six components for α-naphthol-positive.
Further research continued to explore the ability of yeasts to produce BS. Ilori et al. (2008) [58] evaluated the potential for hydrocarbon degradation and the emulsifying activities of BS produced by two yeast strains—Saccharomyces cerevisiae and Candida albicans—obtained from a polluted pond. Both strains grew effectively using crude oil and diesel as carbon sources and the BS exhibited antimicrobial activities against Escherichia coli and Staphylococcus aureus. This work demonstrated that these strains represented a new class of BS producers with the potential for use in a variety of biotechnological and industrial processes, particularly in the pharmaceutical industry. The following year, Hirata et al. (2009) [59] showed production of a glycolipid BS by yeast C. bombicula using soybean oil as a carbon source; this BS exhibited low foaming with high detergency and also presented low cytotoxicity and readily biodegradable properties.
More recently, a BS produced by Rhodotorula sp. using wastewater from olive mills as a substrate has been investigated. The isolated yeast strain was considered a potent producer of a BS that was partially characterized as a complex of glycolipoprotein groups exhibiting interesting properties, such as low critical micellar concentration, a significant reduction in surface tension, strong emulsifying activity, and great potential for application in remobilization of polluted soil hydrocarbons, with a removal rate greater than 95% [36].
Another study evaluated the toxicological profile of polymeric nanoparticles encapsulated in a polylactic acid–polyethylene glycol (PLA–PEG) BS in mice. The BS was isolated from C. parapsilosis and partially characterized by FTIR and GC MS, revealing the presence of a phenol or alcohol group with the possible presence of an amide in the structure. A PLA–PEG copolymer was synthesized using 72 k Da PLA and 6 k Da PEG, and the histopathological results from the selected vital organs revealed that BS and/or encapsulated polymeric nanoparticles can be considered safe since no toxicological characteristics were observed in the tissue histopathology. Therefore, it can be deduced that nanoparticle-encapsulated biosurfactants are non-toxic and can provide a safe and suitable platform for biomedical applications in the future [60].
In addition to yeasts demonstrating high conversions of substrates and their BS products being suitable for applications in the food and pharmaceutical industries—as most do not present risks and have GRAS status—it is clear that BS produced by yeasts have been successful in diverse applications—from antimicrobials to bioremediations and even in the medical field. Therefore, studies of BS produced by yeasts have increased as there is a competitive market between BS and chemical surfactants.
4. Applications of Biosurfactants Produced by Yeast
Diversity of chemical structures of BS leads to a variety of functions (Figure 4), which include their interaction with hydrophobic chemicals. Because of this capacity, BS influence absorption, transport, and biodegradation of hydrocarbons and xenobiotics, which enables bioremediation applications [61]; their ability to form stable micelles enables their application in nanoemulsion formulations and other drug delivery systems used against major diseases, such as thrombosis, Alzheimer’s disease, cancer, etc. [62]. The amphipathic nature of BS allows them to interact with polar and non-polar surfaces, as well as charged surfaces forming the first layer and acting as wetting agents. This amphipathic ability also assists in microbial adhesion and anti-adhesion at interfaces, enabling applications in the pharmaceutical, agricultural, food, and medical industries [63].
Figure 4.
Properties and applications of biosurfactants in the (A) medical/health sector; (B) agricultural sector; (C) environmental sector; and (D) industrial sector. Source: modified from [63].
4.1. Medicine and Health
BS have emerged as promising molecules due to their structural versatility and diverse properties that can be widely used in the pharmaceutical, medical, and cosmetic industries, mainly due to their surface activity. Therefore, BS can be used as antibacterial, antifungal, and antiviral operators; particles safe modulators; antibodies; quality treatments; cancer therapies; constituents of drug delivery systems; or emulsifiers in cosmetics.
Strains Candida albicans and Candida glabrata were used to produce BS, which were then evaluated for their antibacterial properties; the BS of both strains showed antibacterial activity against pathogenic Gram-positive (Bacillus subtilis and Staphylococcus aureus) and Gram-negative (Pseudomonas aeruginosa and Escherichia coli) bacteria at a concentration of 60 mg/L [64]. The antimicrobial and anti-adhesive activity of BS isolated from Candida lipolytica were determined by measuring the percentages of growth inhibition obtained for various microorganisms; it was shown that this BS inhibited growth of different strains of Streptococcus and Staphylococcus aureus by more than 90% at one concentration of 12 mg/L. Recently, the BS produced by yeast Wickerhamomyces anomalus exhibited antibacterial properties against Bacillus cereus, inhibiting and killing the bacterium at a concentration of 60 mg/L [16].
Mannosilitritol lipid (MEL), a glycolipid BS produced by the yeast of the Candida species, has been reported to have neurological and immunological properties, along with antimicrobial potential, while the succinyl trehalose lipid produced by Rhodococcus species could inhibit certain viruses [65]. Yeast Candida bombicola has produced a sophorolipidic BS that exhibited spermicidal activities, was considered hostile to the human immunodeficiency virus (HIV), and was cytotoxic. The diacetate ethyl ester subsidiary of this sophorolipid was the strongest spermicide and virucide in the arrangement of sophorolipids examined [66].
Other works can be found in the literature for these applications, such as the one published by Akiyode et al. (2016) [67] that concluded that BS were effective in retarding the growth of the tested cancer cell lines and, therefore, may be potential candidates for use in human cancer therapy. The physicochemical characteristics of BS suggest that their mechanism of action may be due to activity in the cell membrane.
BS produced by yeast also showed larvicidal activity against larvae of the Aedes aegypt mosquito, which causes diseases such as Dengue, Zika, and Chikungunya. Marcelino et al. (2017) [19] showed that the BS produced by yeast Scheffersomyces stipitis killed 100% of the larvae 12 h after application of BS in concentrations of 800 and 1000 mg/L. Another study showed the larvicidal activity of BS produced by W. anomalus, where 100% of deaths were obtained at a low concentration of 63 mg/L in 24 h [16].
BS can also be used in cosmetics—in the same way as chemically synthesized surfactants—and in detergency, emulsification, demulsification, humidification, foaming, dispersion, solubilization of hydrophobic substances, or modification of surfaces [68]. Takahashi et al. (2012) [69] investigated the antioxidant properties of different MEL derivatives (A, B, and C). All MEL derivatives tested showed antioxidant activity in vitro, but MEL-C, which was produced from soybean oil by Pseudozyma hubeiensis, showed the highest rates of elimination of the DPPH radical (50.3% at 10 mg/mL) and superoxide anion (50% at 1 mg/mL), had greater protective activity against oxidative stress, and showed the highest antioxidant activity (50.3% at 10 g/L). Based on their results, the authors suggested that MELs have potential as anti-aging ingredients for skin care.
4.2. Agriculture
BS can be used to enhance agribusiness as they play an important role in helping microorganism products used for biocontrol, such as parasitism, antimicrobial, rivalry, and protection measures. BS can help organisms to adsorb soil particles surrounded by toxins, thus reducing the dispersion path between the assimilation site and the bio-uptake site by microorganisms. In addition, BS do not have any unfavorable impact on humans or plants and, therefore, can be used in biological control of plant diseases [66]. Use of BS can provide protection to plants directly because of antimicrobial properties against phytopathogenic pathogens and indirectly through the process of stimulating plant defense systems, called the “induced systemic resistance” mechanism; by inducing this mechanism, BS make plants more resistant and less susceptible to attack by pathogens [70].
A sophorolipidic BS produced by yeast Rhodotorula babjevae that was isolated from an agricultural field was evaluated for antifungal activity against phytopathogenic fungi and exhibited promising activity against Colletotrichum gloeosporioides, Fusarium verticilliodes, Fusarium oxysporum, and Trichophyton rubrum. The in vitro antifungal activities of the purified BS were estimated based on the minimum inhibitory concentration (MIC) values and were obtained in the BS concentration range of 62–1000 µg/mL [71].
Another recent work also showed the antifungal activity of a BS produced by yeast against species of phytopathogenic fungi Aspergillus flavus, Aspergillus niger, Cercospora sorghi, Colletotrichum truncatum, Fusarium verticillioides, and Fusarium solani. This BS was produced by yeast W. anomalus and inhibited mycelial growth in up to 95% of all phytopathogenic fungi evaluated in concentrations of 30–50 µg/mL, showing that BS can be applied in agriculture to control diseases and aid in biological control [16].
A study investigated application of modified BS (Figure 5) produced by yeast in plant diseases and produced more evidence of the plant-disease control properties of microbial BS. The investigators reported that BS derivatives exhibited significant antifungal activity against 18 phytopathogens (Alternaria tomatophilia, Alternaria solani, Alternaria alternata, Aspergillus niger, Aureobasidium pullulans, Botrytis cinerea, Chaetomium globosum, Fusarium asiaticum, Fusarium globaminum, Fusarium cereals, Fusarium austroamericana, Fusarium oxysporum, Penicillium chrysogenum, Penicillium digitatum, Penicillium funiculosum, Phytophthora infestans, Phytopthora capsici, and Ustilago maydis) and seven bacterial plant pathogens (Acidovorax carotovorum, Erwinia amylovora, Pseudomonas syringae, Pectobacterium carotovorum, Ralstonia solanacearum, Pseudomonas cichorii, and Xanthomonas campestris). The minimum inhibitory concentrations ranged from 0.009 to 10 mg/mL, and the BS was also effective against zoospores of pathogen Plasmopara viticola, which showed loss of viability and lysis occurring at a concentration of 50–500 μg/mL of BS [72].
Figure 5.
Modified sophorolipids for inhibition of plant pathogens. Source: [72].
4.3. Bioremediation and Oil Recovery
Bioremediation is a process that uses microorganisms to accelerate degradation of environmental contaminants. Biosurfactants increase the surface area, solubility, and bioavailability of hydrophobic water-insoluble substrates, stimulating growth of oil-degrading microorganisms and improving their ability to utilize hydrocarbons [73].
The crude BS produced by yeast Candida lipolytica (UCP 0988) was evaluated for removal of heavy metals and petroleum derivatives. The crude BS removed about 96% of Zn and Cu and reduced the concentrations of Pb, Cd, and Fe from the specimen. The BS removed 20% of the residual oil using a permeability apparatus. The results show that BS can be applied in technologies where removal of heavy metals and petroleum derivatives is desirable. These results demonstrate the versatility of biomolecules of an amphipathic nature [74].
In another study, the BS of Candida sphaerica was tested for demulsification of engine oil emulsions, with values around 40%. The crude BS was able to disperse approximately 90% of the oil droplets in seawater and proved to be non-toxic to the native marine microbiota. These results indicate the potential for applying the BS produced by C. sphaerica in the oil industry as a complement to the remediation processes involving contaminated water [75]. The same group showed the following year that the BS of Candida bombicola also demonstrated the ability to remove oil, with 70% of the engine oil adsorbed to the porous surface. The results obtained with this BS showed this biomolecule’s promising properties for use in bioremediation of hydrophobic compounds [76].
Another study, also involving yeast of the genus Candida, analyzed the BS of Candida lipolytica. The crude BS did not present toxicity for bivalve Anomalocardia brasiliana, for microcrustacean Artemia salina, or for three species of vegetable seeds. It stimulated degradation of motor oil by microorganisms native to seawater, and the cell-free crude extract removed about 30–40% of Pb and Cu from the sand. These results indicate that the BS produced has great potential to be applied as a bioremediation agent in the oil industry for cleaning up oil spills, with additional potential to be used in other industries [77].
Recently, other studies have also shown the potential for BS produced by yeasts in removing engine oil. Derguine-Mecheri et al. (2021) [36] evaluated the BS produced by Rhodotorula sp.YBR and obtained a recovery rate of 98% ± 0.28%. Demonstrating efficient results in the improved removal of hydrophobic contaminants from polluted soils makes this BS a promising potential candidate for environmental applications. In addition, Santos et al. (2021) [78] demonstrated a new formulation of low-cost, biodegradable, and non-toxic BS by Candida sphaerica and investigated the dispersion capacity of engine oil. This biomolecule did not show a cytotoxic effect when placed in contact with the L929 cell line, proving to be harmless to the environment. It has also proven effective in removing oil adsorbed on soil, with a dispersion capacity of 90%, presenting potential in bioremediation applications aimed at recovering environments polluted by oily residues.
In addition to applications in bioremediation and removal of heavy metals from soil, another application evaluated using BS produced by yeast was in bioleaching assays. Meyerozyma guilliermondii showed, in the tests performed, the ability to remove metal in anaerobic sewage sludge and solubilize 15.9% of the sewage sludge’s cadmium [53].
5. Screening Methods for Detection of Biosurfactants
Although several yeast strains are already known to produce BS, many species have been described as new producers of BS; for this reason, there are main methods used to screen, detect, or evaluate potential BS-producing microorganisms, with each having its own advantages and disadvantages (Table 2).
Table 2.
Screening methods to evaluate potential BS-producing microorganisms and their advantages and disadvantages.
5.1. Hemolytic Activity
This is a qualitative screening test for detection of BS producers, in which solid media are used—normally nutrient agar supplemented with 5% fresh whole blood, called blood agar [79]. The isolates are seeded and incubated at the required temperature according to the needs of each microorganism for 48 h. Visual inspection for hemolysis may be an indication of lysis of red blood cells due to rupture of the cell membrane caused by the presence of active surface molecules. Hemolytic activity has been considered an unreliable criterion for detection of BS activity [80]; however, it is very difficult to test the BS productivity of a culture under different conditions directly on the agar [81].
5.2. Blue Agar Plate Method
This technique was developed for detection of glycolipids using mineral salt agar (MSA) supplemented with a carbon source (2%), 0.5 mg/mL of cetyltrimethylammonium bromide (CTAB), and 0.2 mg/mL methylene blue (MB) [82]. This technique uses anionic BS to form a pair of insoluble ions with the CTAB-MB cationic; formation of a dark blue halo around the culture is considered positive for production of BS (Figure 6). It is an excellent technique that has been used widely for detection of BS glycolipids.
Figure 6.
Blue agar plate method. BS positive (dark blue halo). (a,b). Source: [83].
5.3. Agar Plate Overlaid with Hydrocarbons
Pure isolates are plated on Luria–Bertani agar plates coated with hydrocarbons—such as kerosene, hexadecane, benzene, toluene, diesel, or crude oil—and incubated for one week at the desired temperature. Colonies surrounded by an emulsified halo are detected as producers of BS (Figure 7) [84]. This is an efficient method where the observation of an emulsified halo around the culture is a direct indication of the BS producer.
Figure 7.
Agar plate overlaid with hydrocarbons. Positive emulsified halo. Source: [85].
5.4. Axisymmetric Drop Shape Analysis (ADSA)
This technique simultaneously determines the contact angle and the surface tension of the liquid from the profile of a drop on a solid surface (Figure 8). The cells are suspended in a buffer solution or in broth cultures, a drop of each suspension is placed on the surface of fluoroethylene propylene, and the profile of the drop is determined with a counter monitor depending on the time (up to 2 h). The surface stresses of the suspensions are calculated from the droplet profile with ADSA. Only suspensions producing BS show a reduction in surface tension, which depends on the concentration of the product and/or the number of microorganisms producing BS. This technique requires a very small number of cells [86].
Figure 8.
Axisymmetric drop shape analysis. Pendant drop shapes with different surface tensions using a 10 μL drop. Source: [87].
5.5. Modified Drop Collapse Method
Microplates are thinly coated with oil, a 5 μL sample of the culture broth is added to the center of the well, and observations are made for 1 min. If the drop of a sample collapses within the coated oil, it is an indication of the presence of BS in the culture broth [88,89]. This is a technique of rapid detection. However, if the sample contains a small amount of BS, false negative results can occur [80].
5.6. Oil Spreading Method
For this method, 20 μL of oil is added to 50 mL of distilled water in a Petri dish and 10 μL of the culture broth is added to the middle of the surface of the oil-coated water. If there is an emulsified halo around the culture broth, it is considered positive for production of BS (Figure 9) [90]. This is one of the fastest methods for detecting presence of BS producers and is considered efficient.
Figure 9.
Oil spreading method. Positive emulsified halo. Source: [91].
5.7. Emulsification Assay (EA)
The culture broth is centrifuged at 10.000 rpm for 15 min and then 3 mL of the supernatant is mixed with 0.5 mL of oil or hydrocarbon and vortexed vigorously for 2 min. The mix is left undisturbed for 1 h to separate the aqueous and oily phases (Figure 10). The absorbance of the aqueous phase is measured using a spectrophotometer at 400 nm and the uninoculated broth is used as a blank; an absorbance of 0.01 units multiplied by the dilution factor is the unit of emulsification activity per milliliter [92].
Figure 10.
Emulsification assay. Emulsification tests using 1 mL of n-heptane as organic phase and 1 mL of aqueous phase containing increasing amounts of crude BS/BE (0.352 g/L solution)—1: control (0), 2: 100 μL, 3: 200 μL, 4: 325 μL, 5: 350 μL, and 6: 400 μL. Using 350 μL of this crude 100%
emulsion of organic phase is attained. Source: [93].
Recently, Tavares et al. [93] have proposed a quick and reproducible method to determine
the emulsifying activity, based on the ability of biosurfactants/bioemulsifiers
(BS/BE) to form stable emulsions when mixed with n-heptane. In a 4 mL screw cap glass
tube (10 × 75 mm, ND10 caps with PTFE septum) add 1 mL of n-heptane to 1 mL of an
aqueous solution containing the surfactant/cell-free culture broth. Mix vigorously for 2
min, using a vortex, and leave the tube to rest for 10 min in an upright position before
analyzing. Repeat the process with progressively greater volumes of surfactant/cell-free
culture broth until complete emulsification of the organic phase is observed (Figure 10).
With this method, 1 emulsifying unit (1 U) is the minimum volume of product (Volmin of
emulsifier/surfactant, up to 1 mL) needed to form and maintain 100% emulsion in the
organic phase. This can then be used to obtain the emulsifying activity (EA) in U/mL by
EA = 1 U/Volmin (mL) [93]. This method allows the direct comparison between distinct
substances with surfactant properties, giving a quick quantification of substances of multiple
origins and chemical natures.
5.8. Emulsification Index (EI)
Emulsification activity is measured by calculating the height of the emulsion for determining EI. This technique is performed by adding kerosene or oil to the culture broth (1:2 v/v); the tube with the sample and kerosene is vortexed for 2 min and left to stand for 24 h. The height of the emulsion is measured in the layers formed between the aqueous layer and the kerosene layer (Figure 11). EI stability designates the strength of a surfactant [94].
Figure 11.
Emulsification index. (A) Kerosene—negative control; (B) emulsification of kerosene by culture supernatant; (C) diesel oil—negative control; and (D) emulsification of diesel oil by culture supernatant. Source: [95].
5.9. Tensiometric Measurement
Measurement of surface tension using a tensiometer is one of the most common methods in which cell-free supernatant is used. The Wilhelmy plate method, the Du Noüy ring method (Figure 12), the maximum tensile strength method, and the slope drop method are all known for measuring surface tension [96]. It is not feasible to measure surface tension of many isolates at the preliminary selection level because exact measurement of surface tension is difficult to obtain and requires precise equipment and adequate environmental conditions.
Figure 12.
Du Noüy ring method. The force (yellow arrow) referring to the wetted length acting on a ring as a result of the tension of the withdrawn liquid lamella when moving the ring from one phase to another is measured via this method. Source: the author.
6. Biosurfactant Fermentation
Microorganisms can synthesize BS during growth and metabolism; this synthesis usually occurs by resting microbial cell systems, in addition to growth-dependent production. BS are biologically produced from various substrates including hydrocarbons, hydrophobic mixtures, chemicals, solvents, hydrophobic mixtures, vegetable oils, waste oil residues, and dairy products, among others [16,97,98,99]. Therefore, low-cost raw materials are essential for overcoming the high costs of BS production. However, proper management and use of harmful and non-harmful waste generated in the world is necessary [99].
BS synthesis can be natural or induced by presence of different compounds, varying pH values, temperatures, inoculum sizes, aeration, stresses, and agitation speeds. BS yield and production can also be affected by elements such as carbon, nitrogen, iron, sulfur, phosphorus, and manganese [97,100]. More research is essential to optimize production of BS and improve their applications on an industrial scale considering the numerous environmental complexities and factors that limit synthesis and use of BS [101].
There are currently two ways of producing BS: submerged fermentation (SmF), or liquid fermentation, and solid-state fermentation (SSF). SmF is the methodology most used by the scientific community, while SSF is still not very well studied but promising [102]. SSF is a microbial process that occurs mainly on the surface of solid materials that have the property of absorbing or containing water, with or without soluble nutrients [103,104]. Both techniques can use the same producing microorganisms, but the results can be significantly different due to the large differences in conditions between the two types of culture regimes. Furthermore, for a given bioprocess, SSF usually reduces the overall cost compared to liquid fermentation [105] due to the low volume of water used.
Production of biosurfactants in bioreactors is a process that involves monitoring the conditions involved, being essential to choose an appropriate culture method (continuous, batch, or fed-batch), which depends on type of microorganism and type of bioreactor [106,107]. Continuous cultivation of microorganisms is one of the growing methodologies [108] and is mainly characterized by the constant growth rate of the microorganism in a constant environment (parameters such as pH, substrate concentrations, metabolic products, and oxygen are all constant) [6]. Continuous culture of microbes is carried out in bioreactors called chemostats, a type of bioreactor to which the prepared substrate is constantly supplied, while the culture liquid comprising the remaining nutrients, the end products, and the microbial culture is continuously withdrawn simultaneously to maintain a constant culture volume [109,110].
Batch fermentation is widely used in fermentation industries to produce various microbial products. In this process, microorganisms and substrates are supplied to a batch bioreactor for product synthesis [111]. Batch fermentation is a simple way to conduct and ensures controlled environments within the bioreactor. However, during the fermentation process, competitive changes can occur in microbial biomass, acid concentration, and by-product concentration (chapter). The batch bioreactor consists of a mechanically agitated vessel, which may include a gas sprayer, an insulating jacket to regulate temperature changes, a pH meter, and air sprinklers [112,113]. Despite being an easy process, a large expense is involved, and a great deal of time is spent, including emptying, filling, and cleaning bioreactors [114].
The fed-batch process is a customized form of batch fermentation and is more popular in the bioprocessing sector [110]. Microorganisms are inoculated and cultured in the batch system for a period after introducing nutrients into the fermenter to feed them [115]. In fed-batch systems, the constant feed flow of the substrate allows the target secondary metabolites to reach very high concentrations. The benefit of this culture method is that the level of the fed substrate can be managed at the target level [116]. Furthermore, fed-batch systems can be applied when large amounts of biomass are required [117,118].
7. Recovery and Purification of Biosurfactants
Although choice of substrates used in production of BS has an influence on the general process, productivity, and cost of BS, extraction and purification of BS for a marketable product constitutes 60–80% of the total production costs [119]. Therefore, the latest advances in economical and efficient techniques to recover and purify biosurfactants from fermentation broth are reviewed in this study (Table 3).
Table 3.
The latest techniques for recovering biosurfactants from the fermentation broth produced by yeasts.
The most common approaches for recovery and purification of BS involve acid precipitation [122] and extraction of organic solvents, such as ethyl acetate [122], chloroform, and methanol [123]. For further purification, different chromatographic methods have been used [124,125]. However, other methods used to recover BS are also mentioned in this review.
7.1. Acetone Precipitation
After fermentation, the cell-free supernatant is mixed with ice-cold acetone to precipitate the emulsifiers, which are then suspended in a phosphate buffer. Then, the mixture is incubated at 4 °C for 15–20 h to obtain the precipitated BS [126]. This method has been used by several researchers for purification of BS [127,128,129]. It is a fast and relatively inexpensive method without the need for specialized equipment.
7.2. Ethanol Precipitation
As with acetone precipitation, ethanol precipitation uses cell-free fermentation broth, which, normally, is mixed with cold ethanol in a 3:1 ratio (ethanol: culture broth). Invally et al. (2018) confirmed that ethanol precipitation did not cause BS loss. It was shown that ethanol precipitation of BS produced by Acinetobacter calcoaceticus was the most efficient method when compared to other precipitation methods [130].
7.3. Ammonium Sulfate Precipitation
This method uses (NH4)2SO4 for precipitation and is used widely for high-molecular-weight BS and compounds rich in proteins. This method was introduced by Rosenberg et al. (1979) for precipitation of BS from Arthrobacter. For this method, 30% or more of (NH4)2SO4 is used and added directly to the fermentation broth without removing the cells; it is then left to stand overnight. Subsequently, this precipitate is suspended in 3% saturated (NH4)2SO4 and, after centrifugation, is added to the (NH4)2SO4 supernatant again to reach the final concentration of 40%; or, if desired, the resulting precipitate is centrifuged and extracted with ether. Currently, research uses cell-free broth at 4 °C followed by addition of saturated (NH4)2SO4. After cooling, the pellet is resuspended in (NH4)2SO4 and the pellet obtained after centrifugation is dissolved in water and extracted with an equal volume of hexane to remove residues. The product is subsequently purified by dialysis and lyophilized [131,132,133].
7.4. Acid Precipitation
This method is used widely in recovery of BS because it is an easy, inexpensive, and readily available method. The BS is purified from the cell-free supernatant, acid hydrolysis is carried out using concentrated HCl to lower the pH to 2.0, and it is left at 4 °C overnight. The BS becomes insoluble at the low pH [134], and proteins and lipids precipitate [135]. After cooling overnight, the precipitate is centrifuged and the pellet is subsequently extracted using solvents [136,137]. The extracted material is filtered to remove residues and evaporated using a rotary evaporator.
7.5. Centrifugation
After acid precipitation, the broth containing BS can also be centrifuged at 12,000 rpm for 15 min at 4 °C to be easily collected as a crude product. Once the pellet is obtained, it can be dried under N2 and extracted with solvents [137].
7.6. Crystallization
Once the BS is precipitated/extracted, it is redissolved in an organic solvent. The reaction is associated with a reduction in temperature, which crystallizes the BS; therefore, it becomes less soluble in solvents [138].
7.7. Adsorption–Desorption
The interaction of BS molecules with polystyrene resins (XAD 2 or 16) is used for purification of BS since their molecules can be adsorbed and desorbed in these resins. The process is initiated by applying cell-free culture broth directly to the adsorbent column, followed by washing with three volumes of demineralized water to remove unabsorbed compounds. Subsequently, the BS is adsorbed and eluted with three volumes of methanol and removed by evaporation to obtain the crude BS [97]. In this recently developed approach, the BS is adsorbed on polymeric resins and later desorbed with organic solvents. The main advantages of this technique are rapid recovery in one step and obtaining high-quality purified BS.
Dubey and Juwarkar (2005) [139] suggested that adsorption–desorption on wood-based activated carbon can be used because the same carbon can be reused for three consecutive cycles of BS adsorption; this process offers a good example of continuous BS recovery from a fermentation broth using an in situ method that reduces use of high-cost solvents, results in less degradation, and prevents product inhibition.
7.8. Foam Fractionation
This technique was first reported in 1920 and is used to enrich dissolved compounds [140]. The basic principle of this technique is separation of adsorptive bubbles so that the air bubbles generated by an aeration system move to the top of the liquid surface, leading to formation of a foam fraction [141]. A certain amount of liquid is trapped between the air bubbles and is, therefore, lost within the foam; however, the force of gravity causes the trapped liquid to drain, leading to the foam’s collapse. This collapsed foam contains surface and non-surface compounds that are more concentrated than the initial liquid [142]. This technique was previously described and recently used and is considered a low-cost and ecologically acceptable method, suitable for the process of concentrating products diluted in culture media or extracts [132,143].
7.9. Solvent Extraction
For this technique, the BS is concentrated from the supernatant by addition of ZnCl2 and extracted twice with solvents. The organic phases are evaporated to dryness and analyzed using the TLC technique [144]. Hydrophobic portions of BS are soluble in some solvents that aid in the extraction and separation of the crude product. Different solvents—such as chloroform, methanol, ethyl acetate, dichloromethane, butanol, pentane, hexane, acetic acid, diethyl ether, and isopropanol—are commonly used for extraction of BS, but these solvents are toxic and expensive; therefore, it is necessary to use cheaper and less toxic solvents for recovery of BS [96].
8. Characterization of Biosurfactants
Use of analytical chemistry techniques to prove the production of and characterize surfactant compounds is efficient and conclusive. These techniques include thin-layer chromatography (TLC), Fourier transformation infrared spectroscopy (FTIR), high-performance liquid chromatography and mass spectrometry (HPLC–MS), tandem mass spectrometry (MS/MS), and nuclear magnetic resonance (NMR). All these techniques require (partial) purification of surface-active compounds from samples of cell-free supernatants [145]. Different techniques require different levels of sample purity; therefore, it is necessary to be careful with the purity of each sample to obtain significant characterization of surfactant compounds.
8.1. Thin-Layer Chromatography (TLC)
TLC is one of the most used techniques to detect BS. The sample is dissolved in solvents appropriate for each type of analysis and applied to the TLC plate, which is then placed in a closed chamber with the mobile phase (solvent or mixture of solvents). The mobile phase migrates on the plate; thus, the components also migrate but at different rates, resulting in separation. After the race, spots can be seen in UV light or by chemical treatment [146]. To detect BS, the solvent system depends on the type of compound of interest: organic and inorganic solvents that can be dissolved and are not volatile are preferred. Sometimes, acetic acid, diethyl ether, ethyl acetate, n-hexane, and pyridine are necessary for mobility of BS functional groups [96]. A summary of solvents and treatments for visualizing the spots used for detection of different BS produced by yeasts is provided in Table 4.
Table 4.
Solvents and chemical treatments for visualization of TLC spots used for characterization of BS produced by yeast.
8.2. Fourier Transform Infrared Spectroscopy (FTIR)
FTIR has been proposed as a rapid technique that enables identification of surfactant compounds and their quantification [148]. However, FTIR alone should not be used to conclusively identify the type of surfactant compound produced by a microorganism. As an FTIR principle, the chemical bonds present in the compound produce a specific spectrum that can be detected when analyzing a sample in comparison to a known pattern of a specific compound or to patterns that have analogous chemical groups [148]. However, as these chemical bonds are not exclusive to surfactant compounds and can be present in many other extracellular compounds produced by microorganisms, the sample must have a high level of purity to allow this detection to be specific [145]. This technique has been used in a series of studies that report production of BS by yeast strains [21,35,37].
8.3. High-Pressure Liquid Chromatography (HPLC)
This technique consists of a stationary phase (a solid column over which the mobile phase continuously flows the components of the sample solution), a mobile phase (the injected sample solution is carried through the injector port), and a detector (a response is emitted due to sample elution, and, subsequently, a peak in the chromatogram is signaled). In this technique, the components migrate according to the non-covalent interactions of the compound with the column; this separation is based on polarity. Separate products can be detected in individual peaks, and these fractions can be collected for analysis of the structure of each fraction [96,149]. The BS can be separated and identified successively when the HPLC is coupled to an evaporative light-scattering detector (ELSD) or when mass spectrometry (MS) is employed. HPLC, along with MS, is important to provide the molecular mass of each fraction [122].
8.4. Tandem Mass Spectrometry (MS/MS)
The MS/MS technique employs two stages of mass analysis to selectively examine fragmentation of specific ions in an ion mixture. The types of instruments that can be used to perform this experiment are based on separation of mass analysis events over time or measurements on physically separate analyzers [150]. In the MS/MS technique, a single congener can be fragmented and the resultant daughter ions analyzed [151], providing more precision for characterization of BS compounds being produced by microbial strains [145].
8.5. Nuclear Magnetic Resonance (NMR)
This technique is based on transitions of atoms with a magnetic moment when an external magnetic field is applied and absorbance of radiation by a nucleus in a strong magnetic field. Absorption of radiation causes the nuclear spin to realign or rotate in the direction of higher energy; as soon as the energy is absorbed, the nuclei will reissue radiation and return to a low energy state. The transition energy of NMR entirely depends on the intensity of the magnetic field and a factor of proportionality for each nucleus called the magnetogyric ratio. NMR provides information about the functional groups as well as the position of the bonds within the carbohydrate and lipid molecules. The exact location of each functional group can be obtained; information on structural isomers is also possible with the help of a series of NMR experiments and solvents, such as acetic acid, acetone, benzene, chloroform, dimethyl sulfoxide, methanol, pyridine, and water. BS must be dissolved and applied to a series of 1D (1H and 13C) and 2D (such as COZY, TOCSY, HMQC, and HMBC) experiments by NMR and analyzed. This technique has been used to determine chemical structures of BS since 1960 [96,152,153,154].
8.6. Raman Spectroscopy
In biological and chemical systems, Raman spectroscopy has been used successfully to characterize structural conformation, functionalities, and molecular composition of lipid bilayers and surfactant mono- and bilayers—including interdigitation of lipid and surfactant chains or tail groups in bilayers [155,156].
Recently, purified BS extracted from Pseudozyma yeast strains were characterized using the traditional Raman scattering and surface-enhanced Raman scattering methods and exhibited similar vibrations in the regions of 2700−2800 cm−1 and 2850−3050 cm−1, which correspond, respectively, to asymmetric and symmetric C–H stretching vibrations of terminal CH2 and CH3 groups. This work demonstrated that Raman spectroscopy can be a marker-free and efficient method to identify BS and differentiate the level of saturation in an acid chain [157].
9. Final Considerations
Effective screening methodologies and improved purification techniques play a vital role in obtaining better-quality biosurfactants at greater quantities. Biosurfactants produced by yeasts have been shown to be effective in applications in several industrial areas; the possibilities for these applications in the pharmaceutical and food industries are ever increasing. Additionally, yeasts are better producers than bacteria since they produce a greater amount of BS in less time. Currently, the commercial success of biosurfactants is limited by the high cost of production. Therefore, optimized conditions for growth and production, use of renewable and economically viable substrates, and use of microorganisms with higher substrate conversion rates would help to produce more profitable and economically viable biosurfactants.
Author Contributions
Conceptualization, N.d.A.T.F. and D.R.D.; writing—original draft preparation, N.d.A.T.F. and L.A.S.; writing—review and editing, N.d.A.T.F., L.A.S. and D.R.D.; funding acquisition, D.R.D. All authors have read and agreed to the published version of the manuscript.
Funding
This research was supported by Brazilian agencies Conselho Nacional de Desenvolvimento Científico e Tecnológico do Brasil (CNPq) [grant numbers 312336/2014-4, 423095/2016-1], Fundação de Amparo à Pesquisa do Estado de Minas Gerais (FAPEMIG) [grant number CAG-APQ-03478-16], and Coordenação de Aperfeiçoamento de Pessoal de Nível Superior (CAPES) [PNPD20131289].
Institutional Review Board Statement
Not applicable.
Informed Consent Statement
Not applicable.
Acknowledgments
The authors thank Brazilian agencies Conselho Nacional de Desenvolvimento Científico e Tecnológico do Brasil (CNPq), Fundação de Amparo à Pesquisa do Estado de Minas Gerais (FAPEMIG), and Coordenação de Aperfeiçoamento de Pessoal de Nível Superior (CAPES) for the scholarship and financial support. The authors also thank Jacquelyn Gervay Hague for writing assistance and editorial contributions. The authors also thank Susana Paixão and coworkers
[93] for their critical reading and essential suggestion of Section 5.7.
Conflicts of Interest
The authors declare no conflict of interest.
References
- Ribeiro, B.G.; Guerra, J.M.C.; Sarubbo, L.A. Biosurfactants: Production and Application Prospects in the Food Industry. Biotechnol. Prog. 2020, 36, e3030. [Google Scholar] [CrossRef] [PubMed]
- Banat, I.M. Characterization of Biosurfactants and Their Use in Pollution Removal—State of the Art. (Review). Acta Biotechnol. 1995, 15, 251–267. [Google Scholar] [CrossRef]
- López-Prieto, A.; Vecino, X.; Rodríguez-López, L.; Moldes, A.B.; Cruz, J.M. A Multifunctional Biosurfactant Extract Obtained from Corn Steep Water as Bactericide for Agrifood Industry. Foods 2019, 8, 410. [Google Scholar] [CrossRef]
- Banat, I.M.; Makkar, R.S.; Cameotra, S.S. Potential Commercial Applications of Microbial Surfactants. Appl. Microbiol. Biotechnol. 2000, 53, 495–508. [Google Scholar] [CrossRef]
- Silva, E.J.; Rocha e Silva, N.M.P.; Rufino, R.D.; Luna, J.M.; Silva, R.O.; Sarubbo, L.A. Characterization of a Biosurfactant Produced by Pseudomonas Cepacia CCT6659 in the Presence of Industrial Wastes and Its Application in the Biodegradation of Hydrophobic Compounds in Soil. Colloids Surf. B Biointerfaces 2014, 117, 36–41. [Google Scholar] [CrossRef]
- Santos, D.K.F.; Rufino, R.D.; Luna, J.M.; Santos, V.A.; Sarubbo, L.A. Biosurfactants: Multifunctional Biomolecules of the 21st Century. Int. J. Mol. Sci. 2016, 17, 401. [Google Scholar] [CrossRef] [PubMed]
- Díaz De Rienzo, M.A.; Banat, I.M.; Dolman, B.; Winterburn, J.; Martin, P.J. Sophorolipid Biosurfactants: Possible Uses as Antibacterial and Antibiofilm Agent. New Biotechnol. 2015, 32, 720–726. [Google Scholar] [CrossRef]
- Radzuan, M.N.; Banat, I.M.; Winterburn, J. Production and Characterization of Rhamnolipid Using Palm Oil Agricultural Refinery Waste. Bioresour. Technol. 2017, 225, 99–105. [Google Scholar] [CrossRef] [PubMed]
- Garg, M.; Priyanka; Chatterjee, M. Isolation, Characterization and Antibacterial Effect of Biosurfactant from Candida Parapsilosis. Biotechnol. Rep. 2018, 18, e00251. [Google Scholar] [CrossRef]
- Nogueira Felix, A.K.; Martins, J.J.L.; Lima Almeida, J.G.; Giro, M.E.A.; Cavalcante, K.F.; Maciel Melo, V.M.; Loiola Pessoa, O.D.; Ponte Rocha, M.V.; Rocha Barros Gonçalves, L.; Saraiva de Santiago Aguiar, R. Purification and Characterization of a Biosurfactant Produced by Bacillus Subtilis in Cashew Apple Juice and Its Application in the Remediation of Oil-Contaminated Soil. Colloids Surf. B Biointerfaces 2019, 175, 256–263. [Google Scholar] [CrossRef]
- Louhasakul, Y.; Cheirsilp, B.; Intasit, R.; Maneerat, S.; Saimmai, A. Enhanced Valorization of Industrial Wastes for Biodiesel Feedstocks and Biocatalyst by Lipolytic Oleaginous Yeast and Biosurfactant-Producing Bacteria. Int. Biodeterior. Biodegrad. 2020, 148, 104911. [Google Scholar] [CrossRef]
- Fei, D.; Zhou, G.W.; Yu, Z.Q.; Gang, H.Z.; Liu, J.F.; Yang, S.Z.; Ye, R.Q.; Mu, B.Z. Low-Toxic and Nonirritant Biosurfactant Surfactin and Its Performances in Detergent Formulations. J. Surfactants Deterg. 2020, 23, 109–118. [Google Scholar] [CrossRef]
- Perfumo, A.; Rudden, M.; Marchant, R.; Banat, M. Biodiversity of Biosurfactants and Roles in Enhancing the (Bio) Availability of Hydrophobic Substrates. In Cellular Ecophysiology of Microbe, Handbook of Hydrocarbon and Lipid Microbiology; Springer: Cham, Switzerland, 2018; pp. 75–103. ISBN 9783319207964. [Google Scholar]
- Rebello, S.; Anoopkumar, A.N.; Sindhu, R.; Binod, P.; Pandey, A.; Aneesh, E.M. Comparative Life-Cycle Analysis of Synthetic Detergents and Biosurfactants-an Overview; Elsevier Inc.: Amsterdam, The Netherlands, 2019; ISBN 9780128189962. [Google Scholar]
- Fernández-Peña, L.; Guzmán, E.; Leonforte, F.; Serrano-Pueyo, A.; Regulski, K.; Tournier-Couturier, L.; Ortega, F.; Rubio, R.G.; Luengo, G.S. Effect of Molecular Structure of Eco-Friendly Glycolipid Biosurfactants on the Adsorption of Hair-Care Conditioning Polymers. Colloids Surf. B Biointerfaces 2020, 185, 110578. [Google Scholar] [CrossRef] [PubMed]
- Fernandes, N.d.A.T.; de Souza, A.C.; Simões, L.A.; Ferreira dos Reis, G.M.; Souza, K.T.; Schwan, R.F.; Dias, D.R. Eco-Friendly Biosurfactant from Wickerhamomyces Anomalus CCMA 0358 as Larvicidal and Antimicrobial. Microbiol. Res. 2020, 241, 126571. [Google Scholar] [CrossRef] [PubMed]
- Saimmai, A.; Riansa-Ngawong, W.; Maneerat, S.; Dikit, P. Application of Biosurfactants in the Medical Field. Walailak J. Sci. Technol. 2020, 17, 154–166. [Google Scholar] [CrossRef]
- Mnif, I.; Ghribi, D. Glycolipid Biosurfactants: Main Properties and Potential Applications in Agriculture and Food Industry. J. Sci. Food Agric. 2016, 96, 4310–4320. [Google Scholar] [CrossRef] [PubMed]
- Marcelino, P.R.F.; Silva, V.L.; Philippini, R.R.; Zuben, C.J.V.; Contiero, J.; Santos, J.C.; da Silva, S.S.; Ricardo Franco Marcelino, P.; Luiz da Silva, V.; Rodrigues Philippini, R.; et al. Biosurfactants Produced by Scheffersomyces stipitis Cultured in Sugarcane Bagasse Hydrolysate as New Green Larvicides for the Control of Aedes aegypti, a Vector of Neglected Tropical Diseases. PLoS ONE 2017, 12, e0187125. [Google Scholar] [CrossRef] [PubMed]
- Rane, A.N.; Baikar, V.V.; Ravi Kumar, D.V.; Deopurkar, R.L. Agro-Industrial Wastes for Production of Biosurfactant by Bacillus Subtilis ANR 88 and Its Application in Synthesis of Silver and Gold Nanoparticles. Front. Microbiol. 2017, 8, 492. [Google Scholar] [CrossRef]
- Radha, P.; Suhazsini, P.; Prabhu, K.; Jayakumar, A.; Kandasamy, R. Chicken Tallow, a Renewable Source for the Production of Biosurfactant by Yarrowia Lipolytica MTCC9520, and Its Application in Silver Nanoparticle Synthesis. J. Surfactants Deterg. 2020, 23, 119–135. [Google Scholar] [CrossRef]
- Rywińska, A.; Juszczyk, P.; Wojtatowicz, M.; Robak, M.; Lazar, Z.; Tomaszewska, L.; Rymowicz, W. Glycerol as a Promising Substrate for Yarrowia Lipolytica Biotechnological Applications. Biomass Bioenergy 2013, 48, 148–166. [Google Scholar] [CrossRef]
- Campos, J.M.; Stamford, T.L.M.; Sarubbo, L.A. Production of a Bioemulsifier with Potential Application in the Food Industry. Appl. Biochem. Biotechnol. 2014, 172, 3234–3252. [Google Scholar] [CrossRef]
- Chen, C.; Sun, N.; Li, D.; Long, S.; Tang, X.; Xiao, G.; Wang, L. Optimization and Characterization of Biosurfactant Production from Kitchen Waste Oil Using Pseudomonas Aeruginosa. Environ. Sci. Pollut. Res. 2018, 25, 14934–14943. [Google Scholar] [CrossRef]
- Marcelino, P.R.F.; Peres, G.F.D.; Terán-Hilares, R.; Pagnocca, F.C.; Rosa, C.A.; Lacerda, T.M.; dos Santos, J.C.; da Silva, S.S. Biosurfactants Production by Yeasts Using Sugarcane Bagasse Hemicellulosic Hydrolysate as New Sustainable Alternative for Lignocellulosic Biorefineries. Ind. Crops Prod. 2019, 129, 212–223. [Google Scholar] [CrossRef]
- Johnson, P.; Trybala, A.; Starov, V.; Pinfield, V.J. Effect of Synthetic Surfactants on the Environment and the Potential for Substitution by Biosurfactants. Adv. Colloid Interface Sci. 2021, 288, 102340. [Google Scholar] [CrossRef] [PubMed]
- Stuart, M.; Lapworth, D.; Crane, E.; Hart, A. Review of Risk from Potential Emerging Contaminants in UK Groundwater. Sci. Total Environ. 2012, 416, 1–21. [Google Scholar] [CrossRef]
- Siyal, A.A.; Shamsuddin, M.R.; Low, A.; Rabat, N.E. A Review on Recent Developments in the Adsorption of Surfactants from Wastewater. J. Environ. Manag. 2020, 254, 109797. [Google Scholar] [CrossRef] [PubMed]
- Berg, J.C. An Introduction to Interfaces & Colloids: The Bridge to Nanoscience; World Scientific: Singapore, 2010. [Google Scholar]
- Uchegbu, I.F.; Schätzlein, A.G.; Cheng, W.P.; Lalatsa, A. Fundamentals of Pharmaceutical Nanoscience; Springer Science & Business Media: Berlin/Heidelberg, Germany, 2013. [Google Scholar]
- Sharma, D.; Saharan, B.S. Functional Characterization of Biomedical Potential of Biosurfactant Produced by Lactobacillus Helveticus. Biotechnol. Rep. 2016, 11, 27–35. [Google Scholar] [CrossRef]
- Solomon, O.B.; Oluwafemi, A.; Muktar, G.; Mohammed, S.A. Production and Characterization of Biosurfactants by Candida Boleticola H09 and Rhodotorula Bogoriensis H15 for Crude Oil Recovery and Cleaning of Oil Contaminated Fabrics. Int. J. Life Sci. Technol. 2017, 10, 109–123. [Google Scholar]
- Souza, K.S.T.; Gudiña, E.J.; Azevedo, Z.; de Freitas, V.; Schwan, R.F.; Rodrigues, L.R.; Dias, D.R.; Teixeira, J.A. New Glycolipid Biosurfactants Produced by the Yeast Strain Wickerhamomyces Anomalus CCMA 0358. Colloids Surf. B Biointerfaces 2017, 154, 373–382. [Google Scholar] [CrossRef]
- Nwaguma, I.V.; Chikere, C.B.; Okpokwasili, G.C. Effect of Cultural Conditions on Biosurfactant Production by Candida sp. Isolated from the Sap of Elaeis guineensis. Biotechnol. J. Int. 2019, 23, 1–14. [Google Scholar] [CrossRef]
- Camarate, M.C.; Merma, A.G.; Hacha, R.R.; Torem, M.L. Selective Bioflocculation of Ultrafine Hematite Particles from Quartz Using a Biosurfactant Extracted from Candida Stellata Yeast. Sep. Sci. Technol. 2021, 57, 36–47. [Google Scholar] [CrossRef]
- Derguine-Mecheri, L.; Kebbouche-Gana, S.; Djenane, D. Biosurfactant Production from Newly Isolated Rhodotorula sp.YBR and Its Great Potential in Enhanced Removal of Hydrocarbons from Contaminated Soils. World J. Microbiol. Biotechnol. 2021, 37, 18. [Google Scholar] [CrossRef] [PubMed]
- Ribeiro, B.G.; Veras, B.O.; Aguiar, J.S.; Guerra, J.M.C.; Sarubbo, L.A. Biosurfactant Produced by Candida Utilis UFPEDA1009 with Potential Application in Cookie Formulation. Electron. J. Biotechnol. 2020, 46, 14–21. [Google Scholar] [CrossRef]
- Teixeira Souza, K.S.; Gudiña, E.J.; Schwan, R.F.; Rodrigues, L.R.; Dias, D.R.; Teixeira, J.A. Improvement of Biosurfactant Production by Wickerhamomyces Anomalus CCMA 0358 and Its Potential Application in Bioremediation. J. Hazard. Mater. 2018, 346, 152–158. [Google Scholar] [CrossRef] [PubMed]
- Ashby, R.D.; Nuñez, A.; Solaiman, D.K.Y.; Foglia, T.A. Sophorolipid Biosynthesis from a Biodiesel Co-Product Stream. JAOCS J. Am. Oil Chem. Soc. 2005, 82, 625–630. [Google Scholar] [CrossRef]
- Morita, T.; Konishi, M.; Fukuoka, T.; Imura, T.; Kitamoto, D. Microbial Conversion of Glycerol into Glycolipid Biosurfactants, Mannosylerythritol Lipids, by a Basidiomycete Yeast, Pseudozyma Antarctica JCM 10317T. J. Biosci. Bioeng. 2007, 104, 78–81. [Google Scholar] [CrossRef] [PubMed]
- Deshpande, M.; Daniels, L. Evaluation of Sophorolipid Biosurfactant Production by Candida Bombicola Using Animal Fat. Bioresour. Technol. 1995, 54, 143–150. [Google Scholar] [CrossRef]
- Solaiman, D.K.Y.; Ashby, R.D.; Nuñez, A.; Foglia, T.A. Production of Sophorolipids by Candida Bombicola Grown on Soy Molasses as Substrate. Biotechnol. Lett. 2004, 26, 1241–1245. [Google Scholar] [CrossRef]
- Ahmad, Z.; Crowley, D.; Marina, N.; Jha, S.K. Estimation of Biosurfactant Yield Produced by Klebseilla Sp. FKOD36 Bacteria Using Artificial Neural Network Approach. Measurement 2016, 81, 163–173. [Google Scholar] [CrossRef]
- García-Reyes, S.; Yáñez-Ocampo, G.; Wong-Villarreal, A.; Rajaretinam, R.K.; Thavasimuthu, C.; Patiño, R.; Ortiz-Hernández, M.L. Partial Characterization of a Biosurfactant Extracted from Pseudomonas Sp. B0406 That Enhances the Solubility of Pesticides. Environ. Technol. 2018, 39, 2622–2631. [Google Scholar] [CrossRef] [PubMed]
- Günther, M.; Grumaz, C.; Lorenz, S.; Stevens, P.; Lindemann, E.; Hirth, T.; Sohn, K.; Zibek, S.; Rupp, S. The Transcriptomic Profile of Pseudozyma aphidis during Production of Mannosylerythritol Lipids. Appl. Microbiol. Biotechnol. 2015, 99, 1375–1388. [Google Scholar] [CrossRef] [PubMed]
- Rau, U.; Nguyen, L.A.; Roeper, H.; Koch, H.; Lang, S. Fed-Batch Bioreactor Production of Mannosylerythritol Lipids Secreted by Pseudozyma aphidis. Appl. Microbiol. Biotechnol. 2005, 68, 607–613. [Google Scholar] [CrossRef] [PubMed]
- Shekhar, S.; Sundaramanickam, A.; Balasubramanian, T. Biosurfactant Producing Microbes and Their Potential Applications: A Review. Crit. Rev. Environ. Sci. Technol. 2015, 45, 1522–1554. [Google Scholar] [CrossRef]
- Kaur, J.; Kaur, S.; Kumar, M.; Krishnan, P.; Kaur, J.; Priya Minhas, A. Studies on Production, Optimization and Machine Learning-Based Prediction of Biosurfactant from Debaryomyces hansenii CBS767. Int. J. Environ. Sci. Technol. 2022, 19, 8465–8478. [Google Scholar] [CrossRef]
- Lin, X.; Zhou, H.; Zeng, F.; Jiang, L.; Atakpa, E.O.; Chen, G.; Zhang, C.; Xie, Q. A Biosurfactant-Producing Yeast Rhodotorula sp.CC01 Utilizing Landfill Leachate as Nitrogen Source and Its Broad Degradation Spectra of Petroleum Hydrocarbons. World J. Microbiol. Biotechnol. 2022, 38, 68. [Google Scholar] [CrossRef]
- Luna, J.M.; Rufino, R.D.; Campos-Takaki, G.M.; Sarubbo, L.A. Properties of the Biosurfactant Produced by Candida Sphaerica Cultivated in Low-Cost Substrates. Chem. Eng. Trans. 2012, 27, 67–72. [Google Scholar] [CrossRef]
- Ribeiro, B.G.; Campos Guerra, J.M.; Sarubbo, L.A. Production of a Biosurfactant from S. Cerevisiae and Its Application in Salad Dressing. Biocatal. Agric. Biotechnol. 2022, 42, 102358. [Google Scholar] [CrossRef]
- Santos, D.K.F.; Rufino, R.D.; Luna, J.M.; Santos, V.A.; Salgueiro, A.A.; Sarubbo, L.A. Synthesis and Evaluation of Biosurfactant Produced by Candida lipolytica Using Animal Fat and Corn Steep Liquor. J. Pet. Sci. Eng. 2013, 105, 43–50. [Google Scholar] [CrossRef]
- Camargo, F.P.; de Menezes, A.J.; Tonello, P.S.; Dos Santos, A.C.A.; Duarte, I.C.S. Characterization of Biosurfactant from Yeast Using Residual Soybean Oil under Acidic Conditions and Their Use in Metal Removal Processes. FEMS Microbiol. Lett. 2018, 365, fny098. [Google Scholar] [CrossRef]
- Almeida, D.G.; da Silva, R.d.C.F.S.; Luna, J.M.; Rufino, R.D.; Santos, V.A.; Sarubbo, L.A. Response Surface Methodology for Optimizing the Production of Biosurfactant by Candida Tropicalis on Industrial Waste Substrates. Front. Microbiol. 2017, 8, 157. [Google Scholar] [CrossRef]
- Alfian, A.R.; Watchaputi, K.; Sooklim, C.; Soontorngun, N. Production of New Antimicrobial Palm Oil-Derived Sophorolipids by the Yeast Starmerella riodocensis sp. Nov. against Candida Albicans Hyphal and Biofilm Formation. Microb. Cell Factories 2022, 21, 63. [Google Scholar] [CrossRef] [PubMed]
- Pareilleux, A. Hydrocarbon Assimilation by Candida Lipolytica: Formation of a Biosurfactant; Effects on Respiratory Activity and Growth. Eur. J. Appl. Microbiol. Biotechnol. 1979, 8, 91–101. [Google Scholar] [CrossRef]
- Cooper, D.G.; Paddock, D.A. Production of a Biosurfactant from Torulopsis Bombicola. Appl. Environ. Microbiol. 1984, 47, 173–176. [Google Scholar] [CrossRef]
- Ilori, M.O.; Adebusoye, S.A.; Ojo, A.C. Isolation and Characterization of Hydrocarbon-Degrading and Biosurfactant-Producing Yeast Strains Obtained from a Polluted Lagoon Water. World J. Microbiol. Biotechnol. 2008, 24, 2539–2545. [Google Scholar] [CrossRef]
- Hirata, Y.; Ryu, M.; Oda, Y.; Igarashi, K.; Nagatsuka, A.; Furuta, T.; Sugiura, M. Novel Characteristics of Sophorolipids, Yeast Glycolipid Biosurfactants, as Biodegradable Low-Foaming Surfactants. J. Biosci. Bioeng. 2009, 108, 142–146. [Google Scholar] [CrossRef]
- Rana, S.; Singh, J.; Wadhawan, A.; Khanna, A.; Singh, G.; Chatterjee, M. Evaluation of In Vivo Toxicity of Novel Biosurfactant from Candida Parapsilosis Loaded in PLA-PEG Polymeric Nanoparticles. J. Pharm. Sci. 2021, 110, 1727–1738. [Google Scholar] [CrossRef] [PubMed]
- Ren, X.; Zeng, G.; Tang, L.; Wang, J.; Wan, J.; Liu, Y.; Yu, J.; Yi, H.; Ye, S.; Deng, R. Sorption, Transport and Biodegradation—An Insight into Bioavailability of Persistent Organic Pollutants in Soil. Sci. Total Environ. 2018, 610–611, 1154–1163. [Google Scholar] [CrossRef]
- Calabrese, I.; Gelardi, G.; Merli, M.; Liveri, M.L.T.; Sciascia, L. Clay-Biosurfactant Materials as Functional Drug Delivery Systems: Slowing down Effect in the in Vitro Release of Cinnamic Acid. Appl. Clay Sci. 2017, 135, 567–574. [Google Scholar] [CrossRef]
- Markande, A.R.; Patel, D.; Varjani, S. A Review on Biosurfactants: Properties, Applications and Current Developments. Bioresour. Technol. 2021, 330, 124963. [Google Scholar] [CrossRef]
- Gaur, V.K.; Regar, R.K.; Dhiman, N.; Gautam, K.; Srivastava, J.K.; Patnaik, S.; Kamthan, M.; Manickam, N. Biosynthesis and Characterization of Sophorolipid Biosurfactant by Candida spp.: Application as Food Emulsifier and Antibacterial Agent. Bioresour. Technol. 2019, 285, 121314. [Google Scholar] [CrossRef]
- Rodrigues, L.; Banat, I.M.; Teixeira, J.; Oliveira, R.; Rio Oliveira, R. Biosurfactants: Potential Applications in Medicine. J. Antimicrob. Chemother. 2006, 57, 609–618. [Google Scholar] [CrossRef]
- Roy, A. A Review on the Biosurfactants: Properties, Types and Its Applications. J. Fundam. Renew. Energy Appl. 2018, 8, 1–5. [Google Scholar] [CrossRef]
- Akiyode, O.; George, D.; Getti, G.; Boateng, J. Systematic Comparison of the Functional Physico-Chemical Characteristics and Biocidal Activity of Microbial Derived Biosurfactants on Blood-Derived and Breast Cancer Cells. J. Colloid Interface Sci. 2016, 479, 221–233. [Google Scholar] [CrossRef] [PubMed]
- Vecino, X.; Cruz, J.M.; Moldes, A.B.; Rodrigues, L.R. Biosurfactants in Cosmetic Formulations: Trends and Challenges. Crit. Rev. Biotechnol. 2017, 37, 911–923. [Google Scholar] [CrossRef] [PubMed]
- Takahashi, M.; Morita, T.; Fukuoka, T.; Imura, T.; Kitamoto, D. Glycolipid Biosurfactants, Mannosylerythritol Lipids, Show Antioxidant and Protective Effects against H2O2-Induced Oxidative Stress in Cultured Human Skin Fibroblasts. J. Oleo Sci. 2012, 61, 457–464. [Google Scholar] [CrossRef] [PubMed]
- Ongena, M.; Jourdan, E.; Adam, A.; Paquot, M.; Brans, A.; Joris, B.; Arpigny, J.L.; Thonart, P. Surfactin and Fengycin Lipopeptides of Bacillus subtilis as Elicitors of Induced Systemic Resistance in Plants. Environ. Microbiol. 2007, 9, 1084–1090. [Google Scholar] [CrossRef] [PubMed]
- Sen, S.; Borah, S.N.; Bora, A.; Deka, S. Production, Characterization, and Antifungal Activity of a Biosurfactant Produced by Rhodotorula babjevae YS3. Microb. Cell Fact. 2017, 16, 95. [Google Scholar] [CrossRef]
- Schofield, M.H.; Thavasi, T.R.; Gross, R.A. Modified Sophorolipids for the Inhibition of Plant Pathogens. U.S. Patent 2013/00850670 A1, 11 April 2013. [Google Scholar]
- Ron, E.Z.; Rosenberg, E. Biosurfactants and Oil Bioremediation. Curr. Opin. Biotechnol. 2002, 13, 249–252. [Google Scholar] [CrossRef]
- Rufino, R.D.; Rodrigues, G.I.B.; Campos-Takaki, G.M.; Sarubbo, L.A.; Ferreira, S.R.M. Application of a Yeast Biosurfactant in the Removal of Heavy Metals and Hydrophobic Contaminant in a Soil Used as Slurry Barrier. Appl. Environ. Soil Sci. 2011, 2011, 1–7. [Google Scholar] [CrossRef]
- Luna, J.M.; Rufino, R.D.; Jara, A.M.A.T.; Brasileiro, P.P.F.; Sarubbo, L.A. Environmental Applications of the Biosurfactant Produced by Candida Sphaerica Cultivated in Low-Cost Substrates. Colloids Surf. A Physicochem. Eng. Asp. 2015, 480, 413–418. [Google Scholar] [CrossRef]
- Luna, J.M.; Filho, A.S.S.; Rufino, R.D.; Sarubbo, L.A. Production of Biosurfactant from Candida Bombicola URM 3718 for Environmental Applications. Chem. Eng. Trans. 2016, 49, 583–588. [Google Scholar] [CrossRef]
- Santos, D.K.F.; Meira, H.M.; Rufino, R.D.; Luna, J.M.; Sarubbo, L.A. Biosurfactant Production from Candida Lipolytica in Bioreactor and Evaluation of Its Toxicity for Application as a Bioremediation Agent. Process Biochem. 2017, 54, 20–27. [Google Scholar] [CrossRef]
- Santos, E.M.d.S.; Lira, I.R.A.d.S.; Meira, H.M.; Aguiar, J.D.S.; Rufino, R.D.; de Almeida, D.G.; Casazza, A.A.; Converti, A.; Sarubbo, L.A.; de Luna, J.M. Enhanced Oil Removal by a Non-Toxic Biosurfactant Formulation. Energies 2021, 14, 467. [Google Scholar] [CrossRef]
- Banat, I.M. The Isolation of a Thermophilic Biosurfactant Producing Bacillus sp. Biotechnol. Lett. 1993, 15, 591–594. [Google Scholar] [CrossRef]
- Satpute, S.K.; Bhawsar, B.D.; Dhakephalkar, P.K.; Chopade, B.A. Assessment of Different Screening Methods for Selecting Biosurfactant Producing Marine Bacteria. Indian J. Mar. Sci. 2008, 37, 243–250. [Google Scholar]
- Youssef, N.H.; Duncan, K.E.; Nagle, D.P.; Savage, K.N.; Knapp, R.M.; McInerney, M.J. Comparison of Methods to Detect Biosurfactant Production by Diverse Microorganisms. J. Microbiol. Methods 2004, 56, 339–347. [Google Scholar] [CrossRef] [PubMed]
- Siegmund, I.; Wagner, F. New Method for Detecting Rhamnolipids Excreted by Pseudomonas Species during Growth on Mineral Agar. Biotechnol. Tech. 1991, 5, 265–268. [Google Scholar] [CrossRef]
- Wang, Y.; Wan, S.; Yu, W.; Yuan, D.; Sun, L. Newly Isolated Enterobacter cloacae sp. HN01 and Klebsiella pneumoniae sp. HN02 Collaborate with Self-Secreted Biosurfactant to Improve Solubility and Bioavailability for the Biodegradation of Hydrophobic and Toxic Gaseous Para-Xylene. Chemosphere 2022, 304, 135328. [Google Scholar] [CrossRef]
- Morikawa, M.; Ito, M.; Imanaka, T. Isolation of a New Surfactin Producer Bacillus Pumilus A-1, and Cloning and Nucleotide Sequence of the Regulator Gene, Psf-1. J. Ferment. Bioeng. 1992, 74, 255–261. [Google Scholar] [CrossRef]
- Nayarisseri, A.; Singh, P.; Singh, S.K. Screening, Isolation and Characterization of Biosurfactant Producing Bacillus Subtilis Strain ANSKLAB03. Bioinformation 2018, 14, 304–314. [Google Scholar] [CrossRef] [PubMed]
- van der Vegt, W.; van der Mei, H.C.; Noordmans, J.; Busscher, H.J. Assessment of Bacterial Biosurfactant Production through Axisymmetric Drop Shape Analysis by Profile. Appl. Microbiol. Biotechnol. 1991, 35, 766–770. [Google Scholar] [CrossRef]
- Saad, S.M.I.; Neumann, A.W. Axisymmetric Drop Shape Analysis (ADSA): An Outline. Adv. Colloid Interface Sci. 2016, 238, 62–87. [Google Scholar] [CrossRef]
- Jain, D.K.; Collins-Thompson, D.L.; Lee, H.; Trevors, J.T. A Drop-Collapsing Test for Screening Surfactant-Producing Microorganisms. J. Microbiol. Methods 1991, 13, 271–279. [Google Scholar] [CrossRef]
- Bodour, A.A.; Miller-Maier, R.M. Application of a Modified Drop-Collapse Technique for Surfactant Quantitation and Screening of Biosurfactant-Producing Microorganisms. J. Microbiol. Methods 1998, 32, 273–280. [Google Scholar] [CrossRef]
- Morikawa, M.; Hirata, Y.; Imanaka, T. A Study on the Structure–Function Relationship of Lipopeptide Biosurfactants. Biochim. Biophys. Acta-Mol. Cell Biol. Lipids 2000, 1488, 211–218. [Google Scholar] [CrossRef] [PubMed]
- Ashitha, A.; Radhakrishnan, E.K.; Jyothis, M. Characterization of Biosurfactant Produced by the Endophyte burkholderia sp. WYAT7 and Evaluation of Its Antibacterial and Antibiofilm Potentials. J. Biotechnol. 2020, 313, 1–10. [Google Scholar] [CrossRef]
- Patil, J.R.; Chopade, B.A. Studies on Bioemulsifier Production by Acinetobacter Strains Isolated from Healthy Human Skin. J. Appl. Microbiol. 2001, 91, 290–298. [Google Scholar] [CrossRef] [PubMed]
- Tavares, J.; Alves, L.; Silva, T.P.; Paixão, S.M. Design and Validation of an Expeditious Analytical Method to Quantify the Emulsifying Activity during Biosurfactants/Bioemulsifiers Production. Colloids Surf. B Biointerfaces 2021, 208, 112111. [Google Scholar] [CrossRef] [PubMed]
- Cooper, D.G.; Goldenberg, B.G. Surface-Active Agents from Two Bacillus Species. Appl. Environ. Microbiol. 1987, 53, 224–229. [Google Scholar] [CrossRef]
- Sharma, D.; Singh Saharan, B. Simultaneous Production of Biosurfactants and Bacteriocins by Probiotic Lactobacillus casei MRTL3. Int. J. Microbiol. 2014, 2014, 698713. [Google Scholar] [CrossRef]
- Satpute, S.K.; Banpurkar, A.G.; Dhakephalkar, P.K.; Banat, I.M.; Chopade, B.A. Methods for Investigating Biosurfactants and Bioemulsifiers: A Review. Crit. Rev. Biotechnol. 2010, 30, 127–144. [Google Scholar] [CrossRef]
- Gudiña, E.J.; Fernandes, E.C.; Rodrigues, A.I.; Teixeira, J.A.; Rodrigues, L.R. Biosurfactant Production by Bacillus Subtilis Using Corn Steep Liquor as Culture Medium. Front. Microbiol. 2015, 6, 59. [Google Scholar] [CrossRef]
- Ferreira, A.; Vecino, X.; Ferreira, D.; Cruz, J.M.; Moldes, A.B.; Rodrigues, L.R. Novel Cosmetic Formulations Containing a Biosurfactant from Lactobacillus Paracasei. Colloids Surf. B Biointerfaces 2017, 155, 522–529. [Google Scholar] [CrossRef]
- Jimoh, A.A.; Lin, J. Biotechnological Applications of Paenibacillus Sp. D9 Lipopeptide Biosurfactant Produced in Low-Cost Substrates. Appl. Biochem. Biotechnol. 2020, 191, 921–941. [Google Scholar] [CrossRef] [PubMed]
- Darvishi, P.; Ayatollahi, S.; Mowla, D.; Niazi, A. Biosurfactant Production under Extreme Environmental Conditions by an Efficient Microbial Consortium, ERCPPI-2. Colloids Surf. B Biointerfaces 2011, 84, 292–300. [Google Scholar] [CrossRef] [PubMed]
- Jimoh, A.A.; Lin, J. Biosurfactant: A New Frontier for Greener Technology and Environmental Sustainability. Ecotoxicol. Environ. Saf. 2019, 184, 109607. [Google Scholar] [CrossRef]
- Singh, P.; Patil, Y.; Rale, V. Biosurfactant Production: Emerging Trends and Promising Strategies. J. Appl. Microbiol. 2019, 126, 2–13. [Google Scholar] [CrossRef] [PubMed]
- He, Q.; Peng, H.; Sheng, M.; Hu, S.; Qiu, J.; Gu, J. Humidity Control Strategies for Solid-State Fermentation: Capillary Water Supply by Water-Retention Materials and Negative-Pressure Auto-Controlled Irrigation. Front. Bioeng. Biotechnol. 2019, 7, 263. [Google Scholar] [CrossRef]
- Pandey, A. Solid-State Fermentation. Biochem. Eng. J. 2003, 13, 81–84. [Google Scholar] [CrossRef]
- Sadh, P.K.; Duhan, S.; Duhan, J.S. Agro-Industrial Wastes and Their Utilization Using Solid State Fermentation: A Review. Bioresour. Bioprocess. 2018, 5, 1. [Google Scholar] [CrossRef]
- Bernard, A.; Payton, M. Fermentation and Growth of Escherichia coli for Optimal Protein Production. Curr. Protoc. Protein Sci. 1995, 5.3.1–5.3.18. [Google Scholar] [CrossRef] [PubMed]
- Brück, H.; Coutte, F.; Delvigne, F.; Dhulster, P.; Jacques. Optimization of biosurfactant production in a trickle-bed biofilm reactor with genetically improved bacteria. In 25th National Symposium for Applied Biological Science (NSABS); ULiège-Gembloux Agro-Bio Tech-Space: Gembloux, Belgium.
- Amutha, R.; Gunasekaran, P. Production of Ethanol from Liquefied Cassava Starch Using Co-Immobilized Cells of Zymomonas Mobilis and Saccharomyces Diastaticus. J. Biosci. Bioeng. 2001, 92, 560–564. [Google Scholar] [CrossRef] [PubMed]
- Noah, K.S.; Bruhn, D.F.; Bala, G.A. Surfactin Production from Potato Process Effluent by Bacillus Subtilis in a Chemostat. In Twenty-Sixth Symposium on Biotechnology for Fuels and Chemicals; Davison, B.H., Evans, B.R., Finkelstein, M., McMillan, J.D., Eds.; Humana Press: Totowa, NJ, USA, 2005; pp. 465–473. ISBN 978-1-59259-991-2. [Google Scholar]
- Karnwal, A. Biosurfactant Production Using Bioreactors from Industrial Byproducts. In Biosurfactants for a Sustainable Future: Production and Applications in the Environment and Biomedicine; Wiley: Hoboken, NJ, USA, 2021; pp. 59–78. [Google Scholar]
- Vanavil, B.; Perumalsamy, M.; Seshagiri Rao, A. Biosurfactant Production from Novel Air Isolate NITT6L: Screening, Characterization and Optimization of Media. J. Microbiol. Biotechnol. 2013, 23, 1229–1243. [Google Scholar] [CrossRef] [PubMed]
- Behrens, B.; Helmer, P.O.; Tiso, T.; Blank, L.M.; Hayen, H. Rhamnolipid Biosurfactant Analysis Using Online Turbulent Flow Chromatography-Liquid Chromatography-Tandem Mass Spectrometry. J. Chromatogr. A 2016, 1465, 90–97. [Google Scholar] [CrossRef]
- Zhang, Q.; Li, Y.; Xia, L. An Oleaginous Endophyte Bacillus Subtilis HB1310 Isolated from Thin-Shelled Walnut and Its Utilization of Cotton Stalk Hydrolysate for Lipid Production. Biotechnol. Biofuels 2014, 7, 152. [Google Scholar] [CrossRef]
- Probert, H.M.; Gibson, G.R. Investigating the Prebiotic and Gas-generating Effects of Selected Carbohydrates on the Human Colonic Microflora. Lett. Appl. Microbiol. 2002, 35, 473–480. [Google Scholar] [CrossRef]
- Rodriguez-Contreras, A.; Koller, M.; de Sousa Dias, M.M.; Calafell, M.; Braunegg, G.; Marqués-Calvo, M.S. Novel Poly [(R)-3-Hydroxybutyrate]-Producing Bacterium Isolated from a Bolivian Hypersaline Lake. Food Technol. Biotechnol. 2013, 51, 123. [Google Scholar]
- Kazak Sarilmiser, H.; Ates, O.; Ozdemir, G.; Arga, K.Y.; Toksoy Oner, E. Effective Stimulating Factors for Microbial Levan Production by Halomonas smyrnensis AAD6T. J. Biosci. Bioeng. 2015, 119, 455–463. [Google Scholar] [CrossRef]
- Xu, N.; Liu, S.; Xu, L.; Zhou, J.; Xin, F.; Zhang, W.; Qian, X.; Li, M.; Dong, W.; Jiang, M. Enhanced Rhamnolipids Production Using a Novel Bioreactor System Based on Integrated Foam-Control and Repeated Fed-Batch Fermentation Strategy. Biotechnol. Biofuels 2020, 13, 80. [Google Scholar] [CrossRef]
- Yao, S.; Zhao, S.; Lu, Z.; Gao, Y.; Lv, F.; Bie, X. Control of Agitation and Aeration Rates in the Production of Surfactin in Foam Overflowing Fed-Batch Culture with Industrial Fermentation. Rev. Argent. Microbiol. 2015, 47, 344–349. [Google Scholar] [CrossRef]
- Banat, I.M.; Satpute, S.K.; Cameotra, S.S.; Patil, R.; Nyayanit, N.V. Cost Effective Technologies and Renewable Substrates for Biosurfactants’ Production. Front. Microbiol. 2014, 5, 697. [Google Scholar] [CrossRef]
- Kreling, N.E.; Zaparoli, M.; Margarites, A.C.; Friedrich, M.T.; Thomé, A.; Colla, L.M. Extracellular Biosurfactants from Yeast and Soil–Biodiesel Interactions during Bioremediation. Int. J. Environ. Sci. Technol. 2020, 17, 395–408. [Google Scholar] [CrossRef]
- Ribeiro, B.G.; Guerra, J.M.C.; Sarubbo, L.A. Potential Food Application of a Biosurfactant Produced by Saccharomyces Cerevisiae URM 6670. Front. Bioeng. Biotechnol. 2020, 8, 434. [Google Scholar] [CrossRef] [PubMed]
- Smyth, T.J.P.; Rudden, M.; Tsaousi, K.; Marchant, R.; Banat, I.M. Protocols for the Detection and Chemical Characterisation of Microbial Glycolipids. Hydrocarbon and Lipid Microbiology Protocols: Biochemical Methods; Springer: Berlin/Heidelberg, Germany, 2014; pp. 29–60. [Google Scholar] [CrossRef]
- Saikia, R.R.; Deka, S.; Deka, M.; Banat, I.M. Isolation of Biosurfactant-Producing Pseudomonas Aeruginosa RS29 from Oil-Contaminated Soil and Evaluation of Different Nitrogen Sources in Biosurfactant Production. Ann. Microbiol. 2012, 62, 753–763. [Google Scholar] [CrossRef]
- Qiao, N.; Shao, Z. Isolation and Characterization of a Novel Biosurfactant Produced by Hydrocarbon-Degrading Bacterium Alcanivorax Dieselolei B-5. J. Appl. Microbiol. 2010, 108, 1207–1216. [Google Scholar] [CrossRef] [PubMed]
- Weber, A.; Zeiner, T. Purification of Biosurfactants. In Biosurfactants: Production and Utilization—Processes, Technologies, and Economics; CRC Press: Boca Raton, FL, USA, 2014; p. 129. [Google Scholar]
- Pruthi, V.; Singh Cameotra, S. Rapid Method for Monitoring Maximum Biosurfactant Production Obtained by Acetone Precipitation. Biotechnol. Tech. 1995, 9, 271–276. [Google Scholar] [CrossRef]
- Abouseoud, M.; Maachi, R.; Amrane, A.; Boudergua, S.; Nabi, A. Evaluation of Different Carbon and Nitrogen Sources in Production of Biosurfactant by Pseudomonas Fluorescens. Desalination 2008, 223, 143–151. [Google Scholar] [CrossRef]
- Ruangprachaya, F.; Chuenchomrat, P. Isolation and Characterization of Biosurfactant Produced by Lactic Acid Bacteria from Indigenous Thai Fermented Foods. ETP Int. J. Food Eng. 2018, 4, 268–272. [Google Scholar] [CrossRef]
- Bhosale, S.S.; Rohiwal, S.S.; Chaudhary, L.S.; Pawar, K.D.; Patil, P.S.; Tiwari, A.P. Photocatalytic Decolorization of Methyl Violet Dye Using Rhamnolipid Biosurfactant Modified Iron Oxide Nanoparticles for Wastewater Treatment. J. Mater. Sci. Mater. Electron. 2019, 30, 4590–4598. [Google Scholar] [CrossRef]
- Phetrong, K.; H-Kittikun, A.; Maneerat, S. Production and Characterization of Bioemulsifier from a Marine Bacterium, Acinetobacter Calcoaceticus subsp. Anitratus SM7. Songklanakarin J. Sci. Technol. 2008, 30, 297–305. [Google Scholar]
- Joshi, S.J.; Geetha, S.J.; Desai, A.J. Characterization and Application of Biosurfactant Produced by Bacillus licheniformis R2. Appl. Biochem. Biotechnol. 2015, 177, 346–361. [Google Scholar] [CrossRef] [PubMed]
- Najmi, Z.; Ebrahimipour, G.; Franzetti, A.; Banat, I.M. In Situ Downstream Strategies for Cost-Effective Bio/Surfactant Recovery. Biotechnol. Appl. Biochem. 2018, 65, 523–532. [Google Scholar] [CrossRef] [PubMed]
- Vigneshwaran, C.; Vasantharaj, K.; Krishnanand, N.; Sivasubramanian, V. Production Optimization, Purification and Characterization of Lipopeptide Biosurfactant Obtained from Brevibacillus sp. AVN13. J. Environ. Chem. Eng. 2021, 9, 104867. [Google Scholar] [CrossRef]
- Mukherjee, S.; Das, P.; Sen, R. Towards Commercial Production of Microbial Surfactants. Trends Biotechnol. 2006, 24, 509–515. [Google Scholar] [CrossRef] [PubMed]
- Cooper, D.G.; Macdonald, C.R.; Duff, S.J.B.; Kosaric, N. Enhanced Production of Surfactin from Bacillus Subtilis by Continuous Product Removal and Metal Cation Additions. Appl. Environ. Microbiol. 1981, 42, 408–412. [Google Scholar] [CrossRef]
- Thaniyavarn, J.; Roongsawang, N.; Kameyama, T.; Haruki, M.; Imanaka, T.; Morikawa, M.; Kanaya, S. Production and Characterization of Biosurfactants from Bacillus licheniformis F2.2. Biosci. Biotechnol. Biochem. 2003, 67, 1239–1244. [Google Scholar] [CrossRef]
- Nitschke, M.; Pastore, G.M. Production and Properties of a Surfactant Obtained from Bacillus subtilis Grown on Cassava Wastewater. Bioresour. Technol. 2006, 97, 336–341. [Google Scholar] [CrossRef] [PubMed]
- Manso Pajarron, A.; de Koster, C.G.; Heerma, W.; Schmidt, M.; Haverkamp, J. Structure Identification of Natural Rhamnolipid Mixtures by Fast Atom Bombardment Tandem Mass Spectrometry. Glycoconj. J. 1993, 10, 219–226. [Google Scholar] [CrossRef]
- Dubey, K.V.; Juwarkar, A.A. Adsorption—Desorption Process Using Wood-Based Activated Carbon for Recovery of Biosurfactant from Fermented Distillery Wastewater. Biotechnol. Prog. 2005, 21, 860–867. [Google Scholar] [CrossRef]
- Ostwald, W. Verfahren Zum Verdampfen von Flüssigkeiten. Pat. Nr 1920, 327976. [Google Scholar]
- Stevenson, P.; Li, X. Foam Fractionation: Principles and Process Design; CRC Press: Boca Raton, FL, USA, 2014. [Google Scholar]
- Kosaric, N.; Sukan, F.V. Biosurfactants: Production and Utilization—Processes, Technologies, and Economics; CRC Press: Boca Raton, FL, USA, 2014; ISBN 978-1-4665-9669-6. [Google Scholar]
- Merz, J.; Zorn, H.; Burghoff, B.; Schembecker, G. Purification of a Fungal Cutinase by Adsorptive Bubble Separation: A Statistical Approach. Colloids Surfaces A Physicochem. Eng. Asp. 2011, 382, 81–87. [Google Scholar] [CrossRef]
- Tuleva, B.K.; Ivanov, G.R.; Christova, N.E. Biosurfactant Production by a New Pseudomonas Putida Strain. Z. Für Nat. C 2002, 57, 356–360. [Google Scholar] [CrossRef]
- Twigg, M.S.; Baccile, N.; Banat, I.M.; Déziel, E.; Marchant, R.; Roelants, S.; Van Bogaert, I.N.A. Microbial Biosurfactant Research: Time to Improve the Rigour in the Reporting of Synthesis, Functional Characterization and Process Development. Microb. Biotechnol. 2021, 14, 147–170. [Google Scholar] [CrossRef] [PubMed]
- Wall, P.E. Thin-Layer Chromatography: A Modern Practical Approach; Royal Society of Chemistry: Cambridge, UK, 2007; ISBN 0-85404-535-X. [Google Scholar]
- Senthil Balan, S.; Ganesh Kumar, C.; Jayalakshmi, S. Physicochemical, Structural and Biological Evaluation of Cybersan (Trigalactomargarate), a New Glycolipid Biosurfactant Produced by a Marine Yeast, Cyberlindnera saturnus Strain SBPN-27. Process Biochem. 2019, 80, 171–180. [Google Scholar] [CrossRef]
- Leitermann, F.; Syldatk, C.; Hausmann, R. Fast Quantitative Determination of Microbial Rhamnolipids from Cultivation Broths by ATR-FTIR Spectroscopy. J. Biol. Eng. 2008, 8, 13. [Google Scholar] [CrossRef]
- Haba, E.; Abalos, A.; Jáuregui, O.; Espuny, M.J.; Manresa, A. Use of Liquid Chromatography-Mass Spectroscopy for Studying the Composition and Properties of Rhamnolipids Produced by Different Strains of Pseudomonas Aeruginosa. J. Surfactants Deterg. 2003, 6, 155–161. [Google Scholar] [CrossRef]
- De Hoffmann, E. Tandem Mass Spectrometry: A Primer. J. Mass Spectrom. 1996, 31, 129–137. [Google Scholar] [CrossRef]
- Kumari, V.; Tripathi, A.K. Characterization of Pharmaceuticals Industrial Effluent Using GC—MS and FT - IR Analyses and Defining Its Toxicity. Appl. Water Sci. 2019, 9, 185. [Google Scholar] [CrossRef]
- Tulloch, A.P.; Hill, A.; Spencer, J.F.T. Structure and Reactions of Lactonic and Acidic Sophorosides of 17-Hydroxyoctadecanoic Acid. Can. J. Chem. 1968, 46, 3337–3351. [Google Scholar] [CrossRef]
- Asmer, H.J.; Lang, S.; Wagner, F.; Wray, V. Microbial Production, Structure Elucidation and Bioconversion of Sophorose Lipids. J. Am. Oil Chem. Soc. 1988, 65, 1460–1466. [Google Scholar] [CrossRef]
- Agrawal, P.K. NMR Spectroscopy in the Structural Elucidation of Oligosaccharides and Glycosides. Phytochemistry 1992, 31, 3307–3330. [Google Scholar] [CrossRef]
- Suga, K.; Bradley, M.; Rusling, J.F. Probing the Interface of Cast Surfactant Films and an Underlying Metal by Surface-Enhanced Raman Scattering Spectroscopy. Langmuir 1993, 9, 3063–3066. [Google Scholar] [CrossRef]
- Sun, Z.; Park, Y.; Zheng, S.; Ayoko, G.A.; Frost, R.L. Thermal Stability and Hot-Stage Raman Spectroscopic Study of Ca-Montmorillonite Modified with Different Surfactants: A Comparative Study. Thermochim. Acta 2013, 569, 151–160. [Google Scholar] [CrossRef]
- Leu, J.Y.; Yee, J.; Tu, C.S.; Sayson, S.; Jou, Y.S.; Geraldino, P.J. Microstructure and Molecular Vibration of Mannosylerythritol Lipids from Pseudozyma Yeast Strains. Chem. Phys. Lipids 2020, 232, 104969. [Google Scholar] [CrossRef]
Disclaimer/Publisher’s Note: The statements, opinions and data contained in all publications are solely those of the individual author(s) and contributor(s) and not of MDPI and/or the editor(s). MDPI and/or the editor(s) disclaim responsibility for any injury to people or property resulting from any ideas, methods, instructions or products referred to in the content. |
© 2023 by the authors. Licensee MDPI, Basel, Switzerland. This article is an open access article distributed under the terms and conditions of the Creative Commons Attribution (CC BY) license (https://creativecommons.org/licenses/by/4.0/).